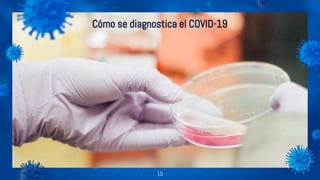
Cómo se diagnostica el COVID-19
10

El documento describe el coronavirus (Covid-19), incluyendo que es una amplia familia de virus que pueden causar desde resfriados hasta enfermedades más graves. Explica que surgió en un mercado de animales en Wuhan, China y se transmite principalmente a través de gotas cuando personas infectadas tosen o estornudan. Los síntomas incluyen fiebre, tos y dificultad para respirar, y la tasa de mortalidad actual es alrededor del 2%. Se han reportado casos en varios países además de China y la OMS recomienda l